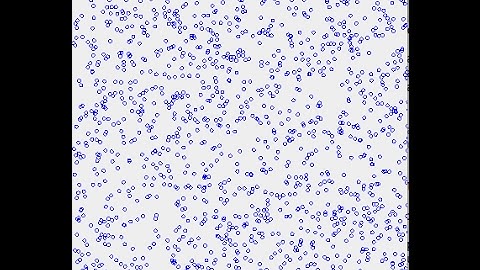
Prog. Project - Random cloud using ArrayList of Point2D.Double (J Graphics)

⬇ DOWNLOAD NOW
Jika muncul iklan pop-up, tutup lalu klik tombol kembali
Download lagu Prog. Project - Polygon using ArrayList (J Graphics) secara gratis hanya untuk keperluan promosi. Dukung artis favorit kamu dengan membeli musik original di iTunes atau platform resmi lainnya.
Prog. Project - Random cloud using ArrayList of Point2D.Double (J Graphics)
Prog. Project - Random cloud using ArrayList of Point2D.Double (J Graphics) Every Design App Depends on This Algorithm — And It’s BAD 💀
Every Design App Depends on This Algorithm — And It’s BAD 💀 3. Making an ARRAYLIST of balls
3. Making an ARRAYLIST of balls Rotating Polygons on the Circle of Fifths | Surprising Results!
Rotating Polygons on the Circle of Fifths | Surprising Results! Point in Polygon test
Point in Polygon test Drawing Polygons 1.8.8 MCP Tutorial #1
Drawing Polygons 1.8.8 MCP Tutorial #1 Polygon - Where our story began.
Polygon - Where our story began. Polygon Location - Interactive 3D Graphics
Polygon Location - Interactive 3D Graphics